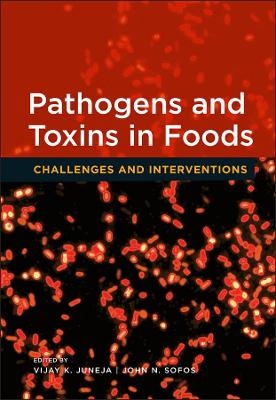
Pathogens and Toxins in Food &ndash; Challenges and Interventions - VK Juneja

Pathogens and Toxins in Food – Challenges and Interventions
2014
American Society for Microbiology (Hersteller)
978-1-68367-131-2 (ISBN)
American Society for Microbiology (Hersteller)
978-1-68367-131-2 (ISBN)
- Keine Verlagsinformationen verfügbar
- Artikel merken
| Erscheint lt. Verlag | 9.4.2014 |
|---|---|
| Sprache | englisch |
| Maße | 150 x 250 mm |
| Gewicht | 666 g |
| Themenwelt | Naturwissenschaften ► Biologie ► Mikrobiologie / Immunologie |
| ISBN-10 | 1-68367-131-7 / 1683671317 |
| ISBN-13 | 978-1-68367-131-2 / 9781683671312 |
| Zustand | Neuware |
| Informationen gemäß Produktsicherheitsverordnung (GPSR) | |
| Haben Sie eine Frage zum Produkt? |